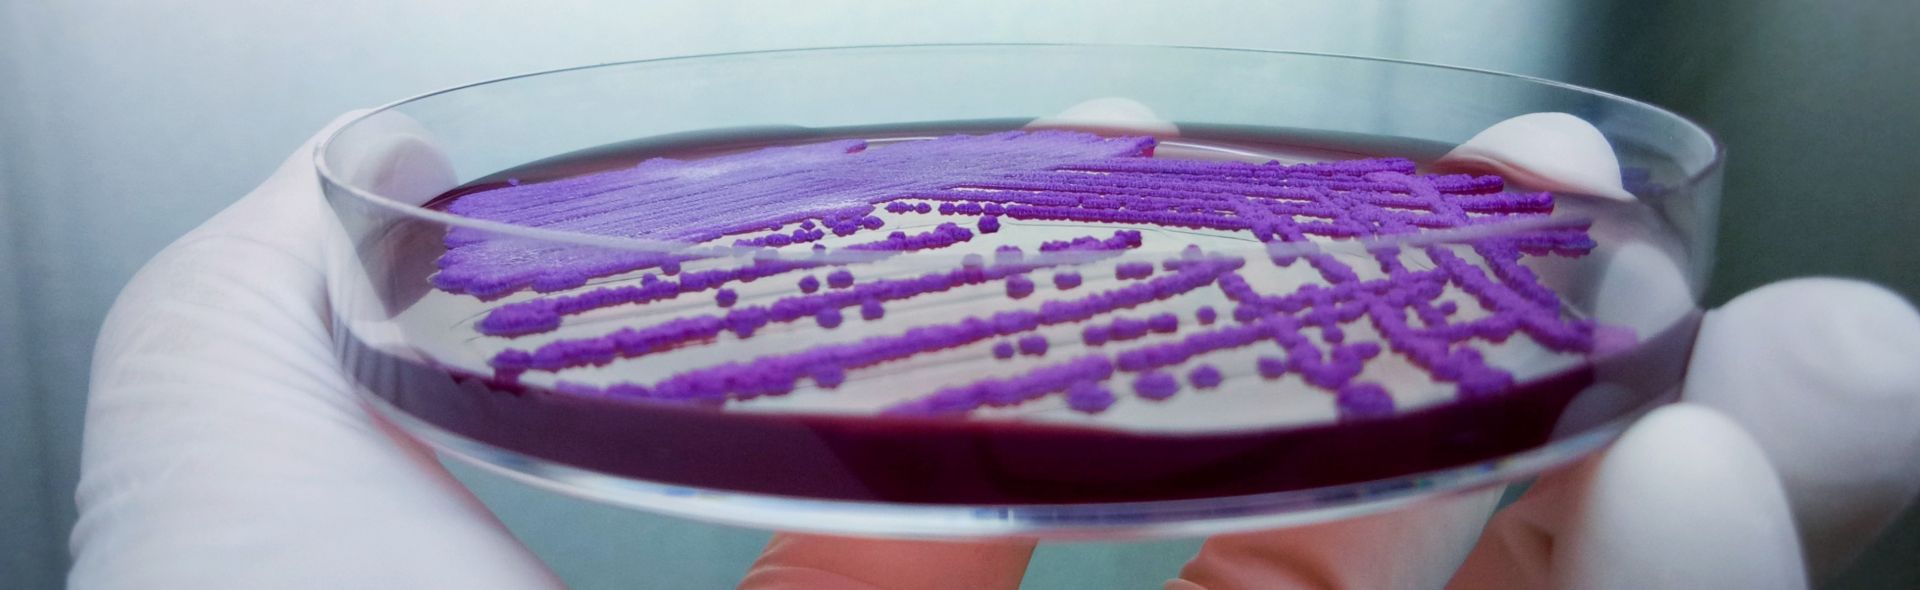

Weekly round-up #82
Weekly round-up #82
It's been a busy week at VALIDATE, with lots of decisions made and, correspondingly, a number of congratulations therefore due to many of our members this week. Firstly, our sixth round of VALIDATE Training Grants has been awarded, with congratulations to Dr Shraddha Siwakoti (B. P Koirala Institute of Health Sciences, Nepal) and Dr Godwin Kwakye-Nuako (University of Cape Coast, Ghana) who will both be going on laboratory exchanges to learn new skills at the University of Leicester and LSHTM respectively. Our next training grant call will open shortly, and you can read more about our funded Training Grants here to get ideas of how you too could use these grants to accelerate your career and build your research collaborators network.
A second set of congratulations are due to the VALIDATE members who have been succesfully awarded a VALIDATE Travel Scholarship to attend our 2019 ECR Workshop, Annual Meeting and BSI co-hosted Scientific Conference in London, UK:
- Asst Prof Vijay Prajapati, Central University of Rajasthan, India
- Asst Prof Lok Bahadur Shrestha, BPKIHS, Nepal
- Dr Olayinka Osuolale, Elizade University, Nigeria
- Dr Federico Carlos Blanco, National Institute of Agricultural Technology, Argentina
- Assoc Prof Narisara Chantratita, Mahidol University, Thailand
- Dr Panjaporn Chaichana, Mahidol University, Thailand
- Asst Prof Kiran Afshan, Quaid-i-Azam University, Pakistan
- Dr Abhishek Mandal, ICMR-Rajendra Memorial Research Institute of Medical Sciences, India
- Dr Chidchamai Kewcharoenwong, Khon Kaen University, Thailand
- Dr Fatoumatta Darboe, MRC The Gambia Unit at LSHTM, The Gambia
- Asst Prof Tufária Mussá, Eduardo Mondlane University, Mozambique
- Dr Eduardo Milton Ramos Sanchez, USP, Brazil
- Dr Suwarti, EOCRU, Indonesia
- Dr Anthony Afum-Adjei Awuah, KCCR, Ghana
If you are interested in attending any of the VALIDATE 2019 events, you can find further details about the programme, including our great list of Keynote speakers, and how to register on our Annual Meeting webpage.
In addition, we are still on the hunt to find our replacement Postdoctoral Bioinformatician/Computational Biologist for VALIDATE. This role is a fantastic postdoctoral opportunity for a proactive bioinformatician or computational biologist to advance their career and become part of a large, engaged international network of vaccinology researchers. The post-holder will be based at the University of Oxford's Jenner Institute with the VALIDATE team and Prof Helen McShane's TB vaccine research group, and will get to work on varied datasets and lead in their analysis as a crucial member of the VALIDATE Network, with the aim of advancing vaccine development for neglected diseases. Find out more about the role here - and please tell any colleagues who might be interested in the vacancy.
- IVVN Laboratory Exchange Awards - To facilitate the transfer of technological experience between laboratories in the Network - deadline 17 Oct 2019
- IVVN Pump-Priming Grants - To allow IVVN members to accelerate their vaccine research by improving vaccine development for livestock and zoonotic diseases in LMICs - deadline 17 Oct 2019
- Newton Fund Institutional Links - For the development of research and innovation collaborations between the UK and partner countries - deadline 9 Aug 2019
- BSI Travel Awards - To support the travel costs for BSI members who wish to attend meetings and congresses - deadlines: 1 Aug; 1 Nov 2019
- BactiVac Catalyst Training Awards - To support training opportunities and exchanges, prioritising those involving LMIC members and academic/industrial partners, for the transfer of knowledge and skills in bacterial vaccinology - open call until Aug 2021
Find more funding opportunities on our website.
Check out our training opportunities page for even more opportunities.
Nothing new this week, all previous external events that we have spotted are listed on our website - and of course don't forget to register for VALIDATE's 2019 events!
- Tuberculosis Epidemiologist - The Institute of Tropical Medicine (ITM), deadline 6 Sep 2019
- VALIDATE Vaccinology Postdoctoral Bioinformatician/Computational Biologist - University of Oxford's Jenner Institute, deadline 28 Aug 2019
- Research Fellow or Assistant Professor - LSHTM, deadline 4 Aug 2019
We keep our website updated with all relevant job and PhD opportunities, so do let us know if you have a vacancy.
- A pathological study of Leishmania infantum natural infection in European rabbits (Oryctolagus cuniculus) and Iberian hares (Lepus granatensis) in Transboundary and Emerging Diseases
- How to fix tuberculosis R&D - the community speaks in Nature Biotechnology
- A Case for Antibodies as Mechanistic Correlates of Immunity in Tuberculosis in Frontiers in Immunology
All relevant publications by our members and others are listed on our publications page. Let us know when you publish a paper and we will share it with the network!
On Twitter this week: An article on how lack of timely detection of leprosy symptoms causes disabilities; read about the Indian-made leprosy vaccine that is set for a large roll out after 36 years of testing; the 2018 G-FINDER report showed that funding for tuberculosis R&D reached it's highest level on record in 2017 but that this is still far short from the estimated $1.3bn needed; more than 100 members of the TB research community marched the LouderThanTB banner for this year's MTN Walk the Talk to raise awareness of TB; and The Global Fund launched their open letter to try encourage the world leaders in France to 'Step Up The Fight' by raising at least $14bn to try and defeat AIDS, TB and malaria by 2030. Take a look at our twitter feed @NetworkVALIDATE to stay up to date.
Published: 31 July 2019